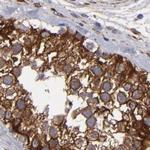
SLMAP Antibody in Immunohistochemistry (Paraffin) (IHC (P))

Search
Invitrogen
SLMAP Polyclonal Antibody
{{$productOrderCtrl.translations['antibody.pdp.commerceCard.promotion.promotions']}}
{{$productOrderCtrl.translations['antibody.pdp.commerceCard.promotion.viewpromo']}}
{{$productOrderCtrl.translations['antibody.pdp.commerceCard.promotion.promocode']}}: {{promo.promoCode}} {{promo.promoTitle}} {{promo.promoDescription}}. {{$productOrderCtrl.translations['antibody.pdp.commerceCard.promotion.learnmore']}}
产品信息
PA5-51708
种属反应
宿主/亚型
分类
类型
抗原
偶联物
形式
浓度
规格
纯化类型
保存液
内含物
保存条件
运输条件
RRID
产品详细信息
Immunogen sequence: SEYEKEITSL QNSFQLRCQQ CEDQQREEAT RLQGELEKLR KEWNALETEC HSLKRENVLL SSELQRQEKE LHNSQKQSLE LTSDLSILQM SRKELENQVG SLKEQHLRDS ADLKTLLSKA ENQAKDVQKE YEKTQTVLSE LKLKFEMTEQ
Highest antigen sequence identity to the following orthologs: Mouse - 93%, Rat - 91%.
靶标信息
Sarcolemmal membrane associated protein (SLMAP) is a tail-anchored membrane protein involved in the docking and membrane fusion process via protein-protein interactions. Deregulation of SLMAP expression plays an important role in type 2 diabetes, and changes in SLMAP expression are linked to hyperglycemia and diabetes. SLMAPs are components of cardiac membranes and have been identified as a novel regulator of cardiac function. There are several isoforms of SLMAPs with varying molecular size (35, 45, 63, and 83-91 kDa) as a result of alternative splicing. The short 35- kDa isoform is predominantly expressed in cardiac and slow-twitch skeletal muscle, while the 83- to 91- kDa isoform is ubiquitous.
仅用于科研。不用于诊断过程。未经明确授权不得转售。
篇参考文献 (0)
生物信息学
蛋白别名: Sarcolemmal membrane-associated protein; Sarcolemmal-associated protein; SLAP1-Alt; unnamed protein product
基因别名: KIAA1601; SLAP; SLMAP; UNQ1847/PRO3577
UniProt ID: (Human) Q14BN4
Entrez Gene ID: (Human) 7871, (Rat) 290533